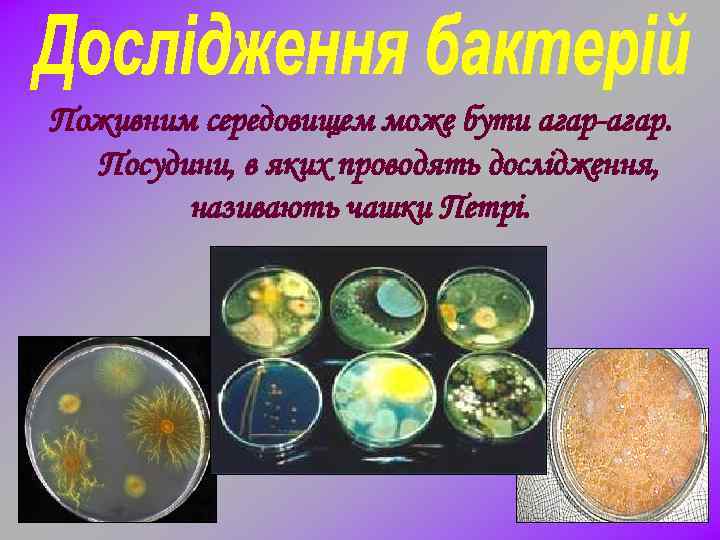
Поживним середовищем може бути агар-агар. Посудини, в яких проводять дослідження, називають чашки Петрі.

Zagalna xarakterystyka bakterij.pptx
- Количество слайдов: 44


Важко знайти місце на Землі, де б не було бактерій. Вони зустрічаються в таких місцях: - в атмосфері, - на дні океанів, - у вічній мерзлоті; - в парному молоці; - в ядерних реакторах; - в кратерах вулканів; в швидкоплинних річках; в живих організмах, але найбільше їх в грунті.

У верхньому шарі грунту містяться мільйони бактерій на 1 г, тобто приблизно 2 тонни на гектар.

Бактерії – найдавніші з усіх відомих організмів. Сліди їх життєдіяльності відносяться до Архею і датуються віком 3, 5 млрд. років.

Бактерії – найдрібніші з організмів, що мають клітинну будову. Їхні разміри складають від 0, 1 до 10 мкм. На одній типографській крапочці можна размістити сотні тисяч бактерій середнього разміру. Побачити бактерії можна тільки в мікроскоп, тому їх називають мікроорганізмами. Наука, що їх вивчає називається мікробіологією. Галузь мікробіології, що вивчає бактерії, називають бактеріологією. Започаткував її Антоні ван Левенгук у XVII ст.

Антоні ван Левенгук та його мікроскоп

У мікробіологічній лабораторії

В бактеріальній клітині відсутнє ядро, хромосоми не відокремлені від цитоплазми оболонкою ядра, а вільно розміщуються в ній. Крім того, в клітині бактерій відсутні ряд органоїдів. Зовні клітинна мембрана оточена клітинною стінкою.



В лабораторіях бактерій вирощують на спеціальному поживному середовищі. Мільйони бактерій утворюють колонії різного кольору та форми.
Поживним середовищем може бути агар-агар. Посудини, в яких проводять дослідження, називають чашки Петрі.

Коки -округлої форми

Бацили -палочковидної форми

Спірили - форма спіралі

Вібріони - форма зігнутої палички, вигляд коми


Стрептококи – вигляд ланцюжка

Стафілококи – вигляд грона

Більшість бактерій рухаються пасивно, за допомогою водних або повітряних течій. Але деякі з них мають джгутики. Вони неначе вгвинчуютсья в середовище, рухаючи клітину вперед.

Монотрихи – мають один джгутик

Лофотрихи – мають віяло джгутиків

Перитрихи – мають джгутики по всій поверхні тіла

Паличка сибірської виразки Зубний наліт Туберкульозна паличка Кишкова паличка

Кисломолочні бактерії Паличка правця Сальмонелла


Pilori бактерія Бульбочкові бактерії Ентеробактерії

Бактерії в крові Бактерії в льоду Бактерії в нафті

За способом живлення бактерії поділяться на автотрофи та гетеротрофи. Ø Автотрофи – бактерії, що не потребують речовин, які виробляються іншими організмами. До них належать пурпурові бактерії, ціанобактерії, залізобактерії, сіркобактерії, азотфіксуючі бактерії. Ø Гетеротрофи – бактерії, що потребують готових органічних речовин. До них належать паразити (збудники хвороб) і сапрофіти ( бактерії гниття чи бродіння).

Бактерії размножуються шляхом поділу навпіл, приблизно кожні 20 хв. у сприятливих умовах. Размноженню перешкоджають сонячні промені та продукти власної життєдіяльності бактерій. Багато з них реагують на зміни температури або зміни освітленності.

Якщо клітина подвоюється кожні півгодини, то за добу вона здатна дати 281474976710656 нащадків.

При несприятливих умовах бактерія вкривається щільною оболонкою, її вміст стає більш густим, життєдіяльність майже припиняється. В такому стані вони можуть годинами знаходитись в глибокому вакуумі і, навіть, переносити температуру від – 240 °С до +100 °С.

Дві найважливіші екологічні функції бактерій: - фіксація азоту; - мінералізація органічних залишків.

Бактерії широко використовуються в харчовій промисловості: - для виробництва сирів та кисломолочної продукції, (творог, простокваша, масло, сметана); - квашення плодів та овочів; - в сільскому господарстві при силосуванні кормів; - оцтовокислі бактерії бродіння використовуються для одержання винного оцту та приготування маринадів.


Бактерії використовуються: - в шкіряній та текстильній промисловості при вимочуванні льону та конопель, при обробці шовку та шкіри; - в мікробіологічній промисловості; - в медицині для приготування сироваток, вакцин, антибіотиків, для виробництва інтерферонів; - в генній інженерії та в біотехнології.

Бактерії використовують для: - вищолочування мідних та уранових руд; - очищення стічних вод від органічних залишків; - боротьби із сільськогосподарськими шкідниками.

Грунтові бактерії беруть участь в утворенні кам’яного вугілля, нафти, торфу … Бактерії гниття разкладають органічні речовини на неорганічні, та роблять їх доступними для рослин. В результаті діяльності бактерій гниття, земля очищається від трупів тварин та рослин, що забезпечує родючість грунтів. Нітрифікуючі та азотофіксуючі бактерії беруть участь в колообігу азоту.

Деякі бактерії поселяються в травному тракті травоїдних ссавців, що забезпечує краще перетравлення їжі, особливо клітковини.

Бактерії приносять не лише користь, але і завдають шкоди: - вони розмножуються в харчових продуктах, викликаючи цим їхнє псування. - з життєдіяльністю деяких бактерій пов’язане біологічне розрушення багатьох промислових матеріалів - дерево, папір, картон…

Бактерії викликають тяжкі захворювання у: людини - туберкульоз, сибірську виразку, ангіну, дифтерію, харчові отруєння, сифіліс, гонорею… тварин - сказ, бруцельоз… рослин - опік яблунь, бактеріоз… Хвороботворні бактерії проникають в організм повітряно-крапельним шляхом, через рани на шкірі та слизових оболонках, через травний канал.

Симптоми хвороб, які викликаються бактеріями, пояснюються дією отрут – токсинів, які виробляються цими мікроорганізмами або отрутами, що утворюються при їх руйнуванні. Ліки, що використовуються проти бактерій руйнують клітинну оболонку самої бактерії, як пеніцилін або блокують роботу рибосом, як стрептоміцин.

- пастеризація - спосіб консервування молока та інших продуктів шляхом однократного нагрівання до 60 -70°С на протязі 15 -30 хв. ; - стерилізація - дія пари з температурою більше 100°С протягом 20 хв. або з допомогою вогню; - охолодження, заморожування, що призупиняє життєдіяльність бактерій; - дезінфекція для знищення хвороботворних бактерій. ультрафіолетове опромінення; - висушування; - консервування;

Zagalna xarakterystyka bakterij.pptx